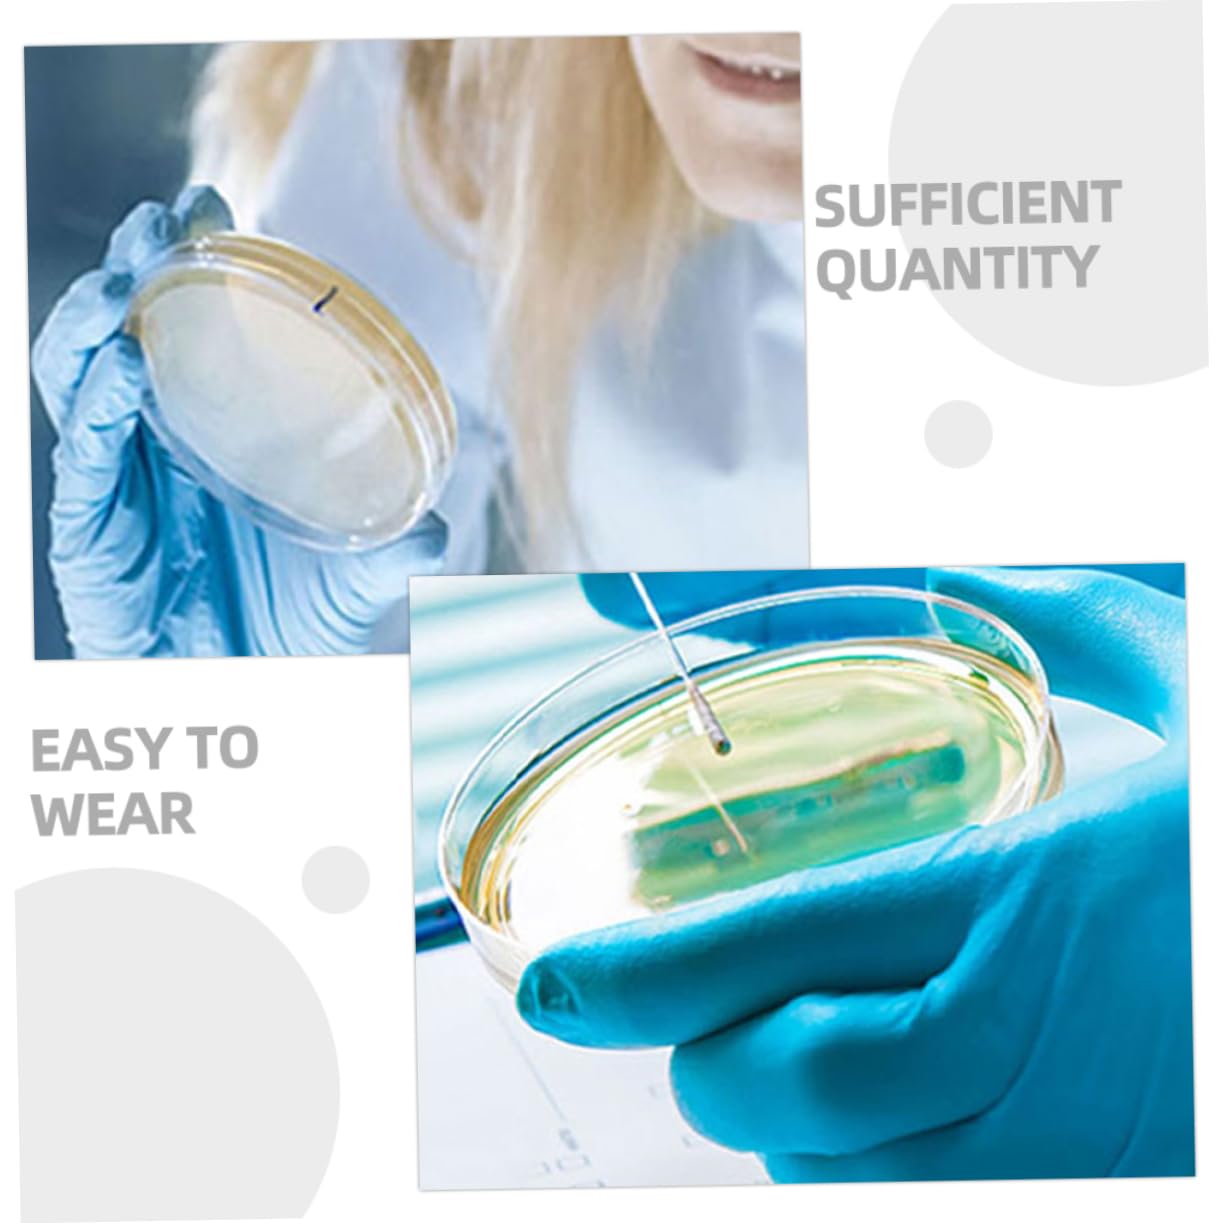
KICHOUSE 20pcs Disposable Petri Dish Culture Dish Agar Culture Dishes with Lids for Science Petri Plates Agar Dish Agar Plates Mushroom Petri Dish with Lid Lab Petri Dishes Plastic

Product Information
Specification
Brand : KICHOUSE
BulletPoint1 : Petri holder with lid:small and lightweight, you can carry petri dishes with you anytime and anywhere,chemistry petri dish
BulletPoint2 : Mushroom agar plates:each set contains enough petri dishes, providing ample supply for multiple experiments,culture dishes with lids for science
BulletPoint3 : Laboratory petri holder:professional chemical experiment tools, these petri dishes make your experiments more successful,culture dishes with lids
BulletPoint4 : Agar plates:made of high-strength material, this petri and not easy to crack or break,petri holder
BulletPoint5 : Laboratory petri plates:these petri dishes are versatile and can be used for a variety of laboratory experiments,chemistry petri holder
Color : As Shown
ItemDisplayDimensions_Length : 2.36 inches
ItemDisplayWeight : 0.22 pounds
ItemName : KICHOUSE 20pcs Disposable Petri Dish Culture Dish Agar Culture Dishes with Lids for Science Petri Plates Agar Dish Agar Plates Mushroom Petri Dish with Lid Lab Petri Dishes Plastic
ItemPackageDimensions_Height : 2.76 inches
ItemPackageDimensions_Length : 5.51 inches
ItemPackageDimensions_Width : 4.72 inches
ItemPackageQuantity : 1
ItemTypeKeyword : science-lab-petri-dishes
ItemVolume : 1 cubic_centimeters
Manufacturer : KICHOUSE
Material : plastic
ModelNumber : 9ZRNIIV163M5G339XAZ05FHJ
NumberOfItems : 1
NumberOfLithiumMetalCells : 1
PartNumber : 9ZRNIIV163M5G339XAZ05FHJ
ProductDescription : Package Include
20 x petri dishes with lids
Characteristics
-Material:Plastic petri dishes with lids
-Size:6.00X6.00X1.00cm/2.36X2.36X0.39in agar petri dishes for mushrooms
-Color:As Shown chemistry petri tray
-Small and lightweight, you can carry petri dishes with you anytime and anywhere petri holder.
-Professional chemical experiment tools, these petri dishes make your experiments more successful petri tray with lid.
-These petri dishes feature clear color and smooth surface to help keep your samples culture dish.
-With lid, this petri dish provides good protection for your samples and easily meets your different needs agar plates mushroom.
-Made of high-strength material, this petri and not easy to crack or break laboratory petri dish.
Goods Description
culture dish agar Our petri dishes are suitable for students to conduct experiments and scientific research.chemistry petri dish for any home, school or laboratory use.laboratory petri holder Sufficient quantity for your use and replacement.chemistry petri holder Widely used in education, chemistry, research or life science
ProductSiteLaunchDate : 2024-11-09T08:08:48.829Z
Size : 6.00X6.00X1.00CM
SupplierDeclaredDgHzRegulation : not_applicable